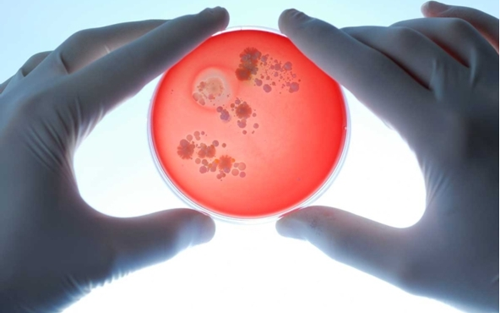

一项新的分析揭示了小鼠如何操控它们胃肠道的微生物,人类或许也是如此。
我们终究还是可以控制我们的肠道的。最近发表的一篇论文阐述了这一诱人的发现,它揭示了小鼠可以控制它们肠道微生物的组成和行为,而人类也有这样的潜能。这一发现颠覆了主流观念。主流观念认为存在于我们肠道中的复杂的生态系统实际上是我们的主人,而我们只是提线木偶而已,它改变我们大脑的生化功能甚至对免疫系统也产生影响,让我们抵抗感染并帮助我们分解过量的汉堡和薯条。
哈佛医学院和波士顿布里格姆妇女医院(Brigham and Women’s Hospital)的研究人员在一系列精心设计的实验中发现小鼠粪便中充满了自其胃肠道的微小的非编码RNA,即microRNAs。这些生物分子可能塑造并调节小鼠体内的微生物。伦敦大学国王学院的遗传流行病学教授 Tim Spector是The Diet Myth: Why the Secret to Health and Weight Loss Is Already in Your Gut的作者,他没有参与这项研究,对此他说道:“多年来我们已经知道微生物会影响人体健康,并且从某种程度上来说我们一直怀疑这是一个双向的过程,但这一想法从来没有被真正地确认。这项研究很好地解释了微生物和我们之间的双向互动关系,它展示了在这个互动关系中,我们是如何影响微生物,这令人着迷。”
更重要的是,研究人员发现人类粪便与小鼠粪便中有17种microRNA相同,这可能预示着人类与小鼠具有相似的机制。这也可能开辟一种包括移植microRNA在内的新的治疗途径。这项研究发表在杂志Cell Host & Microbe上,它的第一作者,哈佛医学院和和波士顿布里格姆妇女医院的神经科学家Howard Weiner说道:“显然,它提出了一个迫切的问题:‘microRNA是从哪里来的,它们为什么在这里?’”

Howard Weiner比较了正常的实验小鼠和那些特意培育出的、消化道中某些种类细胞缺少microRNA的小鼠,来回答“microRNA是从哪里来的”的问题。特殊培育小鼠体内其它细胞的microRNA并未改变,但它们粪便中的microRNAs仍然缺乏,这表明通常位于肠道中的microRNA与粪便中的microRNA之间存在联系。他们从证据中总结出这些特别的RNA来自两种胃肠道上皮细胞。
研究人员也试图通过检查仅有18到23个核苷酸的极小RNA是如何运作来回答“为什么”这个问题。Weiner和他的同事们发现,这些由上皮细胞分泌的microRNA并不只是路人甲。令人惊讶的是,它们的作用似乎非常精妙,并且能调节微生物本身。研究发现体内肠道microRNA少的小鼠更易患结肠炎。但当通过导管向这些病鼠肠道移植了来自正常小鼠的microRNA时,这些患病的小鼠开始产生更正常的肠道物质。没有参与这项研究的Spector说这一系列实验设计很“巧妙”。
在确定这些关键发现后,研究人员还分别发现不同microRNA可以通过更自然的方式改变小鼠体内的特定细菌。研究人员向小鼠的饮用水中加入了有助于大肠杆菌生长的合成microRNA。在饮用这样的水两天后,小鼠粪便中大肠杆菌的含量增加了大概两倍,这证实了引入特定microRNA能够影响肠道。Weiner说:“我认为我们的研究为一种调节微生物的特别方法增加了可能性,我想它还打开了多种可能性。”
此前,许多关于微生物的健康益处的焦点都集中在粪便移植的医疗应用上,它是将一个人的粪便移植到另一个人的结肠中,以期矫正受体肠道中的细菌。但是用不同microRNA去调节不同种类的细菌可能是一个非常有吸引力的替代方案。这是因为,从理论上讲,与进行粪便移植并且确保它的安全相比,使用来自测序结果的基因草图来制造microRNA的模仿品(其与microRNA的作用对象相同)要更简单,而且更有针对性。







